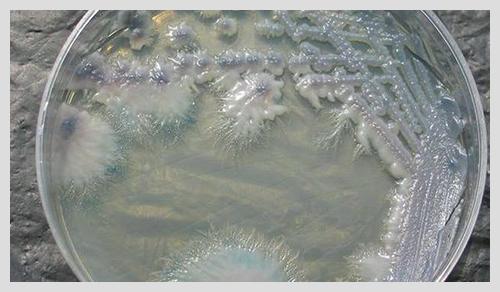
全球技巧菌 v2-3d210e21a36bdb8f3df0cade652db196_r.jpg

全球技巧菌_全球技巧菌
*** 次数:1999998 已用完,请联系开发者***

?^? 90%的人都不知道!爱的世界里这些小技巧能让感情升温你以为爱情就只能平平淡淡地过?那可大错特错啦!其实在爱的世界里,有很多小技巧能让你们的感情迅速升温,可90%的人都不知道呢!接下来我就给你好好唠唠这些超实用的小技巧。 首先,时不时来点小惊喜绝对是感情升温的利器。想象一下,TA辛辛苦苦工作一天回到家,本以为又是平淡的...

必看!糖尿病患者如何在世界杯期间健康观赛?这些技巧快收藏你可以利用比赛间隙起身活动活动,伸伸懒腰、踢踢腿。如果条件允许,还可以在客厅里简单地跳跳绳。运动就像给你的身体充电,能让你更有精神地看球,也有助于控制血糖。 总之,糖尿病患者在世界杯期间也能健康观赛,只要在饮食、作息和运动上多注意。掌握了这些技巧,你就能尽情享...
![]()
自由式滑雪空中技巧世界杯阿拉木图站:中国队夺得1金1银1铜本文转自:人民网人民网北京3月3日电 (记者胡雪蓉)北京时间3月2日,2024-2025赛季国际雪联自由式滑雪空中技巧世界杯阿拉木图站结束争夺。中国选手王心迪、齐广璞分别夺得男子个人项目金牌和铜牌,徐梦桃收获女子个人项目银牌。 男子个人项目资格赛共有32人参加,其中包括6名中...

自由式滑雪空中技巧世界杯北大湖站:中国1队获混合团体冠军2月24日,在2024-2025赛季国际雪联自由式滑雪空中技巧世界杯北大湖站混合团体决赛中,由徐梦桃、齐广璞、李天马组成的中国1队以345.26的成绩获得金牌,由陈梅婷、王心迪、李心鹏组成的中国2队以316.72的成绩获得铜牌。来源:央视新闻举报/反馈

+▂+ 自由式滑雪空中技巧世界杯北大湖站收官 中国队收获3金2银1铜本文转自:人民网人民网北京2月25日电 (记者胡雪蓉)2月24日,2024-2025赛季国际雪联自由式滑雪空中技巧世界杯北大湖站落幕。中国队包揽男、女个人项目及混合团体赛冠军,在本站比赛取得3金2银1铜的成绩。 中国自由式滑雪空中技巧队在哈尔滨亚冬会上表现出色,收获4金4银2铜。...
ˋ0ˊ
自由式滑雪空中技巧世界杯北大湖站:中国队获3金2银1铜2024-2025赛季自由式滑雪空中技巧世界杯北大湖站24日落幕,中国队共收获3金2银1铜。在当日进行的混合团体比赛中,由徐梦桃、齐广璞、李天马组成的中国一队获得金牌,由陈梅婷、王心迪、李心鹏组成的中国二队摘铜。2月24日,中国队徐梦桃在决赛中。新华社记者 颜麟蕴 摄决赛第...
╯▽╰ ![]()
自由式滑雪空中技巧世界杯北大湖站收官:中国队包揽三冠中新网吉林2月24日电 (记者 石洪宇)2024—2025赛季国际雪联自由式滑雪空中技巧世界杯北大湖站24日收官。当天进行的混合团体赛中,由徐梦桃、齐广璞、李天马组成的中国一队获得冠军,由陈梅婷、李心鹏、王心迪组成的中国二队获得季军,亚军由美国一队获得。 中国选手李...

ˋ△ˊ 自由式滑雪空中技巧 世界杯中国队揽双冠2月23日,2024—2025赛季国际雪联自由式滑雪空中技巧世界杯在吉林北大湖举行。中国选手李天马、徐梦桃分别将男子和女子金牌收入囊中,齐广璞、陈梅婷分获男子、女子银牌,当日的冠、亚军席位全部归属中国队。 李天马在家门口举办的世界杯拿到了第一枚世界杯金牌,&ldq...

●▂● 自由式滑雪空中技巧世界杯北大湖站:中国选手揽“双冠”中新社吉林2月23日电 (记者 石洪宇)2024—2025赛季国际雪联自由式滑雪空中技巧世界杯北大湖站23日举行决赛。中国选手李天马、徐梦桃分别获得男子组、女子组冠军。 本站比赛共有中国、加拿大、瑞士、美国、芬兰、澳大利亚等国家的近60名运动员参加。 自由式滑雪空中...
●^● 自由式滑雪空中技巧世界杯:中国队包揽个人项目金银牌新华社长春2月23日电(记者李典、颜麟蕴)2024-2025赛季自由式滑雪空中技巧世界杯北大湖站23日开赛。在当日进行的个人项目中,中国选手徐梦桃和陈梅婷包揽女子金、银牌,李天马和齐广璞携手获得男子前两名。 女子决赛共有12名参赛选手,中国队六人晋级。第一轮比赛过后,成绩排...

蜗牛加速器部分文章、数据、图片来自互联网,一切版权均归源网站或源作者所有。
如果侵犯了你的权益请来信告知删除。邮箱:xxxxxxx@qq.com